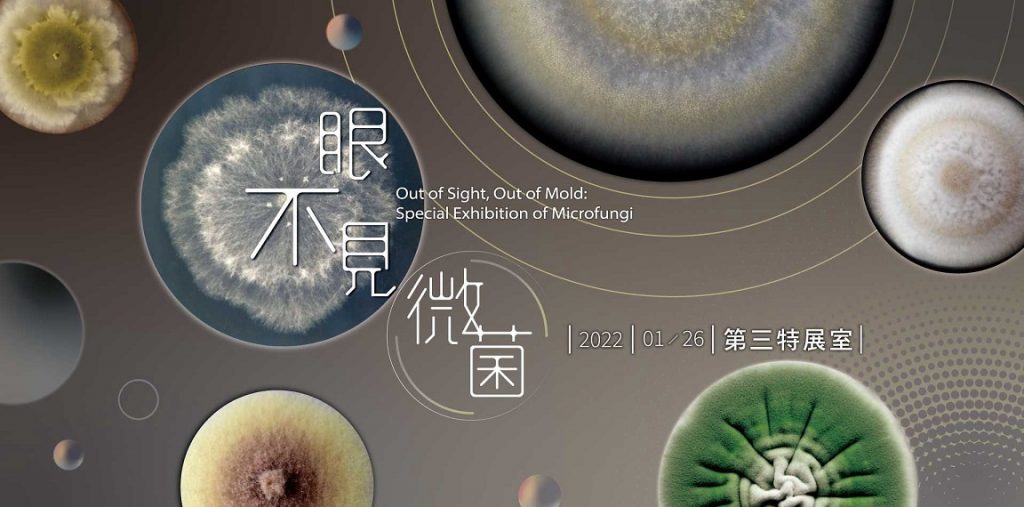
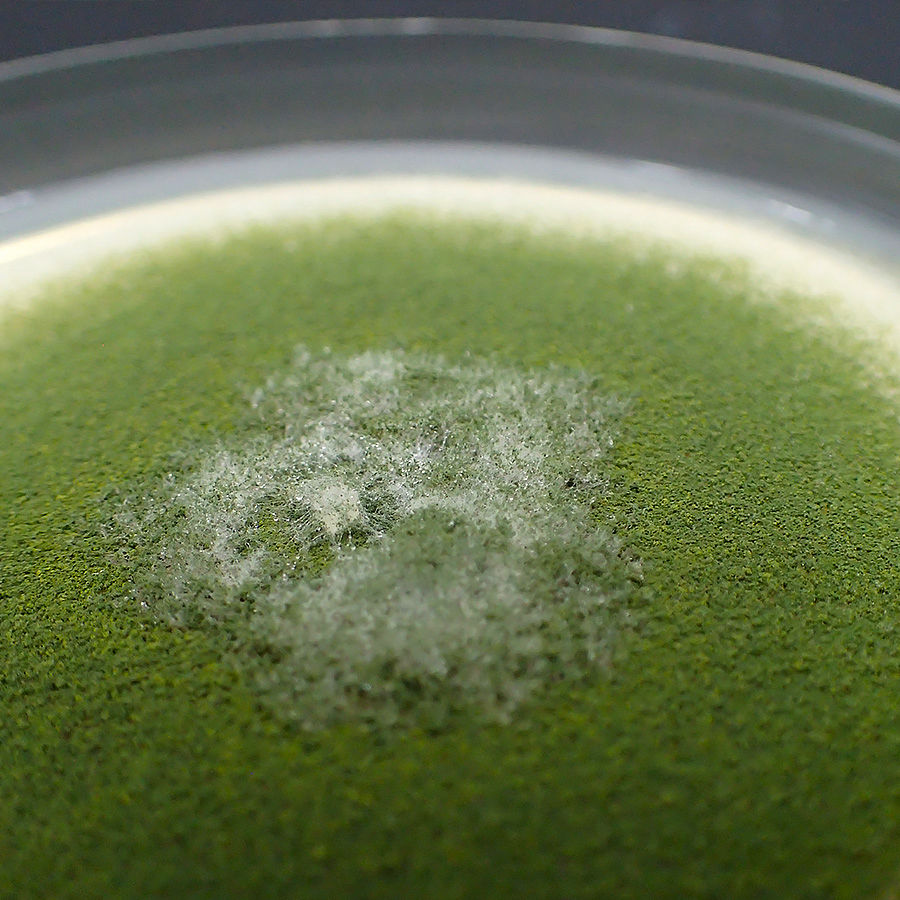
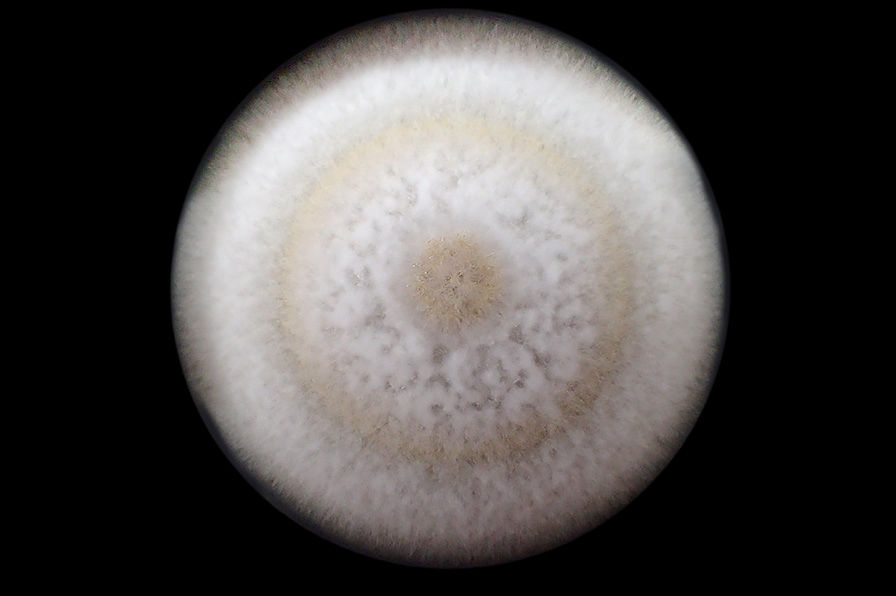

微真菌泛指肉眼無法辨識、看不到的真菌,談到微真菌,我們往往直覺聯想到發霉的食物、陰暗潮濕的角落,但你知道微真菌不只可用於飲食、有些還能用於治病嗎?
國立自然科學博物館自推出《眼不見微菌—微真菌特展》,透過深入淺出的四大單元展示,帶大眾認識這些肉眼無法辨識的微真菌特性。
(圖片來源:國立自然科學博物館)
策展人黃俞菱博士表示,一般大眾對真菌的認知有限,但其實微真菌和生態系中其他生物、人類生活關係密切,觀眾可透過本特展了解科博館如何發現、保存與研究真菌的生物多樣性,從生態、生活、與學術研究等多元面向認識微真菌。
日常生活中,我們常覺得「眼不見為淨」,但看不見髒東西就絕對乾淨嗎?
事實上,我們周遭環境中布滿了各式各樣的細菌、病毒、真菌和藻類等眼睛看不到的微生物,這次特展的主角,正是這些微生物中的「微真菌」。
展覽除了介紹真菌與微真菌的特性,也藉由植物內生真菌、菌根菌、植物病原真菌、地衣及蟲生真菌等,說明微真菌在生態系中與植物、動物和其他生物間的關係,再藉由生活中常見的各種微真菌產品,談到微真菌與人類生活的密切關係。最後,則帶觀眾進一步了解在科博館的實驗室中,如何發現、保存與研究真菌的生物多樣性。
除了從多元面向揭露微真菌在生態系中的多樣關係,策展人張瀛之分享,這次特展要闡述一個重要概念—
眼睛看不到的微真菌,本身並無「好」、「壞」之分,只是當它們和不同生物、物質與環境交互作用過程中,可能對不同的生物帶來或「好」或「壞」的影響。

(圖片來源:國立自然科學博物館)
「真菌世界」單元首先從形態、生活史介紹真菌這群和植物一樣不會動,但親緣關係卻和動物比較接近的特別生物,觀眾可從窺視孔互動裝置與菌盤中一探微真菌真面目,輕鬆認識微真菌和細菌的差別。

大型真菌
微真菌
「是敵是友?微真菌與其他生物」單元則以植物真菌、地衣和蟲生真菌為例,說明微真菌與其他生物間緊密的共生關係,像是常在樹幹、岩石上常發現的地衣,其實是微真菌與藻類或藍綠菌的共生體;寄生在昆蟲身上、導致寄主死亡的蟲生真菌,則是常被作為抑制農作病蟲害的生物防治農藥。

微真菌與植物 
地衣 
蟲生真菌


無論你我是否意識到,微真菌早已深入我們的生活,緊接著的「眼不見為淨?生活中的“好”“壞”菌」展區,就從日常飲食、用品、醫療健康層面切入,舉凡各種酒類、發酵茶,醬油、味噌、紅麴等調味料,豆腐乳、起司、天貝等發酵食品與東西方麵食,以及清潔劑、飲料、化妝品、醫療用藥、健康食品等日常用品,我們的飲食與生活處處充滿著微真菌。然而,不當儲存會造成食物發霉、產生真菌毒素,環境、人體健康狀況不佳時也會引發真菌性疾病,這些則讓人聞之色變。

微真菌與飲食的恩怨情仇微真菌與人類的飲食文化密不可分, 
日常用品中的微真菌──生活用品中許多重要成分是微生物的產物 。 
微真菌與健康──微真菌可以是導致你我生病的罪魁禍首,也可以是救命良藥。 
環境黴菌真菌喜歡高溫、潮濕的環境。保持通風、乾燥與清潔,是阻絕黴菌生長的重要方法。

本特展最後一單元「菌種保存庫」,以科博館的真菌實驗室一隅為場景,帶觀眾一窺博物館如何透過真菌蒐藏庫保存乾燥標本,以真菌種原庫長期保存活菌株,讓未來的研究有更多可能。
真菌培養──利用培養基可以使看不見的微真菌大量生長 
菌種保存法──真菌學家為長期保存菌株,發展出各種菌株保存法

《眼不見微菌—微真菌特展》特展展出至11月27日止,歡迎觀眾把握機會踴躍參觀,相關展覽內容與科教活動陸續更新於科博館官網。
眼不見微菌─微真菌特展
展覽時間|2022/01/26 – 2022/11/27
展覽地點|國立自然科學博物館第三特展室
小典藏ArtcoKids|小編報報( 1553篇 )追蹤作者喜歡藝術,熱愛繪本,最愛閱讀,還有開懷大笑的小孩笑容! 每天都愛四處看東看西趴趴走,要把最新鮮有趣好看好玩的內容分享給大家!
★按讚FB→https://www.facebook.com/artcokids/
▲來追IG→ https://www.instagram.com/artcokids/
■聽PODCAST→ https://open.firstory.me/user/artcokids
◎加LINE@→https://line.me/R/ti/p/@hmo6185j
◣一起玩→ 合作洽談 artcokids@gmail.com